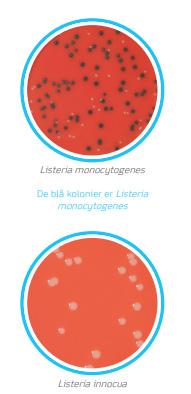

RAPID’L.mono & RAPID’Salmonella
Listeria monocytogenes og Salmonella spp. er de 2 vigtigste årsager til dødsfald på grund af fødevarebåren sygdom i Europa.
Derfor er der også i Forordning om mikrobiologiske kriterier for fødevarer (2073/2005) beskrevet, både fødevaresikkerhedskriterier og proceshygiejnekriterier for disse bakterier.
Vores chromogene RAPID-medier er selektive medier til detektion og eventuelt kvantificering af en række forskellige patogene bakterier.
RAPID’Salmonella
Princippet bag RAPID’Salmonella er anvendelse af to forskellige enzymer aktivitet. Salmonella spp. vokser som typiske, let identificerbare magenta kolonier (der er dannet pga. af C8 esterase). Modsvarende anvendes en anden farve, dannet pga. Beta-D-gluconidase, til at afsløre andre bakterier.
→ Hurtig resultat på mindre end 42 timer
→ Økonomisk:
1 opformering samt 1 plade
→ BPW-opformering kan anvendes til prøvefortyndinger
→ Nem at bruge, let konfirmering → Fleksibel i brug
→ Meget lavt antal falske positive (<1% alle matrices) under ISO 16140 studie
RAPID’L.mono
RAPID’L.mono mediet er et selektivt medie til direkte påvisning og tælling af Listeria monocytogenes og Listeria spp. i levnedsmidler og miljøprøver.
→ RAPID’L.mono Medie til påvisning af Listeria på 24 timer
→ Tælling af L. mono på kun 24 timer
→ Ingen konfirmering iht. NordVal validering
→ Nem at aflæse med farvereaktion
→ Påvisning af L. mono efter 24 timers opformering
→ Høj sensitivitet og specificitet
• L. monocytogenes påvisning 24 timer efter opformering
• Listeria spp. påvisning 24 og 48 timer efter opformering
• L. monocytogenes tælling på 24 timer uden konfirmering
RAPID’Salmonella
RAPID’L.mono er den eneste chromogene metode, der er valideret til L. monocytogenes og Listeria spp. detektion på den samme plade. RAPID’L.mono kan også anvendes til tælling eller konfirmation af L. monocytogenes.
Metoden anvender godkendte alternative principper til tælling og påvisning af Listeria monocytogenes og Listeria spp. i levnedsmidler og miljøprøver.
På det røde agar ses Listeria monocytogenes som blå kolonier, mens andre Listeria arter kan differentieres som hvide kolonier med eller uden opklaringszone og Listeria ivanovii ses som grønne kolonier med gul opklaringszone.
Metoden bruges også i ISO 11290-1, som den sekundære agar AFNOR og NordVal valideret med alternativ metode “1 opformering – 1 plade protokol”.
Kontakt vores produktspecialist for mere information
Ehsan Mirsharghi
Ehsan@fooddiagnostics.dk
Tlf: 22 22 75 92
FØDEVARESIKKERHED I HØJSÆDET
Detekterbart plast
Undgå kontaminering med detekterbart plast
Risikoen for fysisk kontaminering af det færdige fødevareprodukt med fremmedlegemer kan ikke udelukkes, selvom produktionsprocesserne lever op til de højeste standarder. For at eliminere denne fare kan man anvende udstyr og redskaber der kan detekteres af hhv. metaldetektorer eller X-ray maskiner i virksomhdens produktionslokale. På denne måde kan man forsikre sig om, at der ikke er kommet fremmedlegemer i produktet.
Visuel sporing med godkendt
HACCP-farvekodning
Vi kan tilbyde farvekodet udstyr for at adskille, hvilken funktion de forskellige genstande har, og f.eks. hvilken afdeling de hører til.
Denne løsning muliggør visuel sporing af en eventuel fødevarekontaminering, samtidig med at den mindsker risikoen for krydskontaminering. Her får du et overblik over, hvilke farver det detekterbare plastik findes i:
Den blå farve er ofte anvendt i fødevareindustrien. Her udnytter man, at farven blå ikke forekommer naturligt i fødevarer. Lad os hjælpe dig med at gøre din produktion endnu mere sikker, ved at udstyre din produktion med farvekodede redskaber i en af de mange tilgængelige farver.
Mulighed for både visuel og mekanisk sporing
Da plastikken er fremstillet i et detekterbart materiale, er der mulighed for at opnå høj sikkerhed, da der både kan foretages en visuel og en mekanisk sporing, samtidig med, at de følger HACCP-standarderne.
Overblik over produktsortiment indenfor detekterbart plastik
På næste side ses udpluk af vores sortiment, så det er muligt at få et overblik over, hvor bredt det spænder.
Alle produkterne fås som metaldetekterbare og mange af dem også som X-ray detekterbare
Husk at teste din metaldetektor
For at være sikker på, at du kan stole på de resultater, din metaldetektor giver, er det væsentligt, at den bliver testet, således at den altid giver et korrekt billede af produktionen.
Vi tilbyder et bredt udvalg af forskellige produkter til test og kalibrering af metaldetektorer og X-Ray maskiner, Fe, nonFe og SS316 i forskellige størrelser.
Senest nyt: MÅTTER
”Sticky Mats” er den perfekte løsning ved indgang til rene områder, da der samles snavs, som overføres fra sko.
Hver måtte består af 30 nummererede lag (fx et for hver dag i måneden).
En anden mulighed er magnetiske måtter, designet specielt til anvendelse mellem værksteder og produktionsområder (BRC Global Standard 4.7.7).Endeligt findes der også mikrobielt behandlede måtter med dræning.
1. Kontorartikler
• Kuglepenne
• Clips
• Kortholdere
• Linealer
• Clipboards
• Hæftemaskiner
2. Beklædning
• Hatte
• Overtrækssko
• Skægbind
• Skåneærmer
• Ørepropper
• Engangshårnet
• Plastre
3. Værktøj og udstyr
• Skovle
• Kander
• Omrører
• Spande
• Koste
• Børster
• Kabelstrips
• Sikkerhedsknive
Kontakt vores produktspecialist for mere information
Thomas Bundgaard
Kontakt vores produktspecialister for mere information Thomas Bundgaard thomasb@fooddiagnostics.dk Tlf: 4268 7218
Thomasb@fooddiagnostics.dk Tlf: 42 68 72 18
HÅNDHOLDTE REFRAKTOMETRE
Måling af pH, Brix, salt og syreindhold er nogen af de oftest udførte målinger ved fødevarefremstilling. Tit vil disse målinger være vigtige i henhold til virksomhedens risikoanalyse.
En præcis og hurtig måling er derfor vigtig i forhold til at sikre en god kvalitet af fødevarerne. Resultaterne giver mulighed for at kontrollere og optimere produktionen, ved løbende at måle koncentrationerne i råvarer, halvfabrikata og færdigvarer.
Food Diagnostics forhandler håndholdte digitale refraktometre, som med en lille prøvemængde, hurtigt og nemt kan give dig resultat. De er meget robuste og kan klare den nogle gange hårde behandling måleinstrumenter udsættes for i en produktion. Desuden er de IP65 godkendte og kan tåle at blive afskyllet under rindende vand.
PAL-salt:
Salt er også med til at inhibere vækst af mikroorganismer, men lige så vigtigt er det kvalitetsmæssige aspekt i, at både færdigvarer og eksempelvis
saltlage har et præcist indhold af salt.
PAL-salt kan, som de andre håndholdte instrumenter, tåle af bliver afskyllet under rindende vand.
PAL-Alpha:
Grader Brix (°Bx) som måles med dette refraktometer, er et mål for de opløste faste stoffer i en væske og bruges almindeligvis til at måle indholdet af opløst sukker.
Måling af Brix i fødevareindustrien kan både anvendes i forbindelse med kvalitetskontrol og proceskontrol.
PAL-pH:
Fødevarers pH-værdi måles både ved kvalitetskontrol og af fødevaresikkerhedsmæssige årsager, hvis en fødevare ikke har den korrekte pH, er der risiko for, at der kan ske uønsket mikrobiologisk vækst.
PAL-pH kan måle pH med kun 0,6 mL (svarende til ca. 3 dråber) prøve, og det tager kun 3 sekunder. Dette er langt nemmere og hurtigere end ved pH-måling med probe. Det kræver ingen kemikalier, og forbruget af kalibreringsbuffere er langt lavere.
PAL-BX | ACID:
Med PAL-BX|ACID kan parametrene for frugt - sukker (Brix) og surhedsgrad måles med én enhed. Den måler sukkerniveauet (Brix) gennem en refraktometrisk metode ved hjælp af lysbrydning. Den måler også surhedsniveauet gennem elektrokonduktivitetsmetode ved hjælp af elektrisk strøm.
Forskellen på pH og mængden af syre: Der er en sammenhæng mellem pH og syreniveau, men deres grundlæggende principper er forskellige. pH er et udtryk for hydrogenionerne (H+)-koncentration i en opløsning. pH kan give et groft skøn over syreværdien af stærke syrer, såsom saltsyre, men det er svært at vurdere syreværdien af svage syrer, såsom organiske syrer, ved hjælp af pH.
Konventionel syre-base titrering, kræver store mængder reagenser og bortskaffelse af disse efter analyse.
ATAGO Brix-syremålere kræver ingen reagenser overhovedet.
For at måle surhedsgraden skal prøven fortyndes med vand, placeres på instrumentets linse og der trykkes på START-knappen. Alle kan nemt tage disse målinger. PAL-BX|ACID fås til en lang række frugter, samt øl, eddike, mælk og yoghurt.
SE MERE HER!
Kontakt vores produktspecialist for mere information
Kontakt vores Tech Support for mere information
Katarina Petrucic Katarina@fooddiagnostics.dk
Tlf: 25 94 80 86
Michelle Frandsen michelle@fooddiagnostics.dk +45 2040 7099
Biokemi Danmark
Cristiana@foodiagnostics.dk Telefon: 2594 8086
Det er sommer og badetid - måske har du bemærket at der er forskel på, om du hopper i bølgen blå i Danmark eller ude i Verden. Indholdet af salt (Natriumchlorid) ligger på mellem 30 og 40 promille (tusindedele) i det, som betegnes som saltvand. Brakvand, som i f.eks. Østersøen har et saltindhold på ca. 8 promille.
Færøerne
Runi Nielsen Tonny NielEhsan Mirsharghi Mikrobiologi Danmark
Runi@foodiagnostics.dk Telefon: (298) 591667
Ehsan@foodiagnostics.dk Telefon: 2222 7592 Hygiejne & ECA Danmark
Tonny@foodiagnostics.dk Telefon: 4056 5659
Dette er for at undgå spredning af invasive arter. Den nemmeste måde at måle saltindholdet på, er at bruge et refraktometer. Der findes refraktometre til havvand, som angiver indholdet i promille og i relativ densitet.
Thomas Bundgaard Hygiejne
Danmark
thomasb@fooddiagnostics.dk
Tlf: 42 68 72 18
Saltindholdet kan være vigtigt at måle, bl.a. på skibe, som har brug for at lukke vand ud af ballasttankene. Ifølge lovgivningen, skal koncentrationen af salt indgå i den risikoanalyse, som går forud for udledningen.
Naturligvis findes der også refraktometre, der kan måle andre opløsninger af salt, eksempelvis i saltlager. Desuden findes en model med probe, så det er muligt at måle i faste prøver som fisk, rogn, pølser og ost.
Food Diagnostics deltager i LabDays den 13. og 14. september 2023 i Aarhus Congress Center.
Kom og mød vores produktspecialister og tech support og se og hør om vores spændende produkter.
Ehsan Mirshargi Mikrobiologi
Danmark
KURSER 2023
Scan QR-koden og læs mere
KONTAKT
Vi afholder løbende kurser.
• WEBINAR VEDR. HYGIEJNE-KONTROL DEN 9. OKTOBER 2023
ehsan@fooddiagnostics.dk
Tlf: 22 22 75 92
Katarina Petrucic Techsupport
Danmark
katarina@fooddiagnostics.dk
Tlf: 25 94 80 86
Rúni Nielsen Produktspecialist
Færøerne
runi@fooddiagnostics.dk
Tlf: (+298) 591 667
Food Diagnostics A/S
Søndre Kajgade 7-9
8500 Grenaa
Danmark
Tlf: 8759 1666
Mail: info@fooddiagnostics.dk
På www.fooddiagnostics.dk og tilmeld dig vores digitale nyhedsbrev eller ’’følg’’ os på Facebook, Linkedln eller YouTube
Michelle Frandsen Techsupport
Danmark
michelle@fooddiagnostics.dk
Tlf: 20 40 70 99